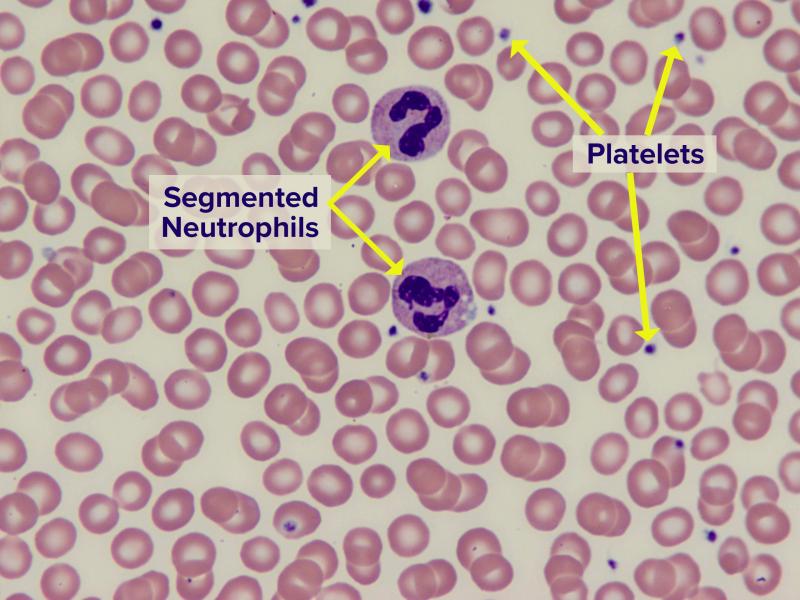
Image of normal blood smear

To evaluate any change in the number of red blood cells in your blood
Red Blood Cell Count
As part of a full blood count (FBC), which may be requested for a variety of reasons.
A blood sample taken from a vein in your arm or by a finger-prick (children and adults) or heel-prick (newborns)
No test preparation is needed
-
How is it used?
A RBC count is used to evaluate any type of decrease in red blood cells (anaemia) or increase in red blood cells (polycythaemia).
-
When is it requested?
A RBC count is normally requested as a part of the full blood count (FBC), which may be requested for many different reasons.
-
What does the test result mean?
A high RBC count may indicate congenital heart disease, dehydration, obstructive lung disease, sleep apnoea or bone marrow over-production. A low RBC count may indicate anaemia, bleeding, kidney disease, bone marrow failure (for instance, from radiation or a tumour), malnutrition, or other causes. A low count may also indicate nutritional deficiencies of iron, folate and vitamin B12.
-
Is there anything else I should know?
Normal decreases in red blood cells are seen during pregnancy as a result of normal body fluid increases that dilute them.
Living at high altitudes causes an increase in RBC counts—this is your body’s response to the decreased oxygen available at these heights.
-
How are abnormal red blood cell counts treated?
First, your doctor must determine the cause of your abnormal RBC count so that they can prescribe appropriate treatment. Treatment may include a vitamin or mineral supplement, a change in your nutrition, removal of excess red blood cells or replacement with red blood cells from a blood donor. Alternatively, it may only require changing your current medication or prescribing a drug to stimulate red cell production in your bone marrow.
-
Can I test my RBCs at home?
No. This test is performed by trained laboratory personnel in an accredited laboratory using specialist equipment.
-
Do diet and nutrition help keep RBCs at healthy levels?
Yes, to the extent that if you eat a well-balanced diet, you can prevent iron deficiency anaemia and vitamin B12 or folate deficiency. RBC problems that are caused by disease conditions are not likely to be corrected by diet.
-
Are there symptoms I should recognise if my RBCs are dangerously low or high?
Tiredness may indicate a low RBC count. Fainting, pallor (loss of normal skin colour), and shortness of breath also can indicate low RBCs, as do dizziness and an altered mental state that may be the result of dehydration.
When the RBC is high it may cause headaches, visual disturbances and a flushed appearance to the skin.